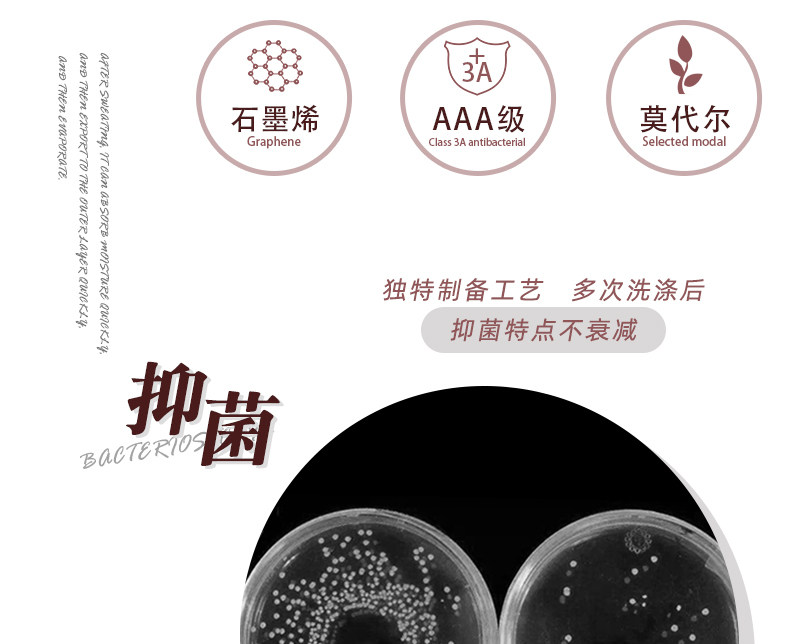

【正品石墨烯】无钢圈睡觉穿内衣女石墨烯
68.9元
¥269
(2.6折)
(100笔成交)
【正品石墨烯】无钢圈睡觉穿内衣女石墨烯 【正品石墨烯】无钢圈睡觉穿内衣女石墨烯,无钢圈睡觉穿内衣女石墨烯内暖小胸聚拢调整型修身美背睡眠文胸,防胸部下垂,超级舒适,石墨烯正品文胸,不舒服包退【送运费险】

53.9 78.9
53.9 78.9  https://img.alicdn.com/imgextra/i2/707433487/O1CN01GVeS0X1bd5gOsTTxQ_!!707433487.jpg 天猫 50 25
https://img.alicdn.com/imgextra/i2/707433487/O1CN01GVeS0X1bd5gOsTTxQ_!!707433487.jpg 天猫 50 25
你可能还喜欢
云上有品-柒幺玖福利站719优惠券-每日精选超值优惠商品-719-qiyaojiu-优惠券是一个中立的,致力于帮助广大网友买到更有性价比网购产品的分享平台,每天为网友们提供最受追捧 最具性价比 最大幅降价潮流新品资讯。我们的信息大部分来自于网友爆料,如果您发现了优质的产品或好的价格,不妨给我们爆料(谢绝商家)。点此爆料





 京ICP备18051242号
京ICP备18051242号
发表回复
要发表评论,您必须先登录。